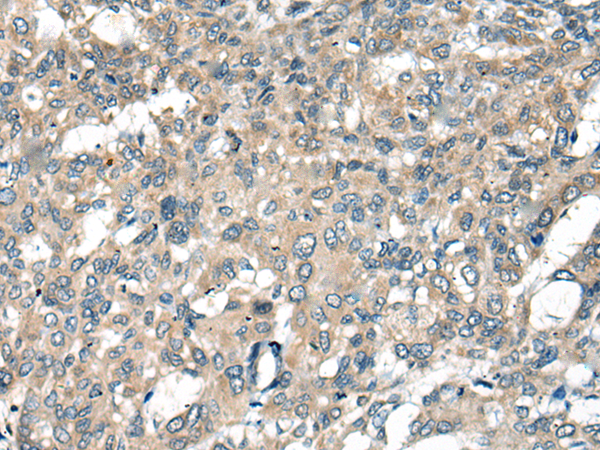

中文名稱: 兔抗ACKR2多克隆抗體
英文名稱: Anti-ACKR2 rabbit polyclonal antibody
別 名: atypical chemokine receptor 2; D6; hD6; CCR9; CCBP2; CCR10; CMKBR9
相關類別: 一抗
抗 原: ACKR2
儲 存: 冷凍(-20℃)
宿 主: Rabbit
反應種屬: Human
標 記 物: Unconjugate
技術規(guī)格
|
Background: |
This gene encodes a beta chemokine receptor, which is predicted to be a seven transmembrane protein similar to G protein-coupled receptors. Chemokines and their receptor-mediated signal transduction are critical for the recruitment of effector immune cells to the inflammation site. This gene is expressed in a range of tissues and hemopoietic cells. The expression of this receptor in lymphatic endothelial cells and overexpression in vascular tumors suggested its function in chemokine-driven recirculation of leukocytes and possible chemokine effects on the development and growth of vascular tumors. This receptor appears to bind the majority of beta-chemokine family members; however, its specific function remains unknown. This gene is mapped to chromosome 3p21.3, a region that includes a cluster of chemokine receptor genes. |
|
Applications: |
ELISA, WB, IHC |
|
Name of antibody: |
ACKR2 |
|
Immunogen: |
Synthetic peptide of human ACKR2 |
|
Full name: |
atypical chemokine receptor 2 |
|
Synonyms: |
D6; hD6; CCR9; CCBP2; CCR10; CMKBR9 |
|
SwissProt: |
O00590 |
|
ELISA Recommended dilution: |
5000-10000 |
|
WB Predicted band size: |
43 kDa |
|
WB Positive control: |
Human placenta tissue lysate |
|
WB Recommended dilution: |
200-1000 |

購物車
購物車 幫助
幫助
 021-54845833/15800441009
021-54845833/15800441009
